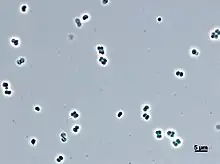
Abditibacterium utsteinense

Abditibacteriota
| Abditibacteriota | |
|---|---|
![]() | |
| Abditibacterium utsteinense | |
| Scientific classification | |
| Domain: | Bacteria |
| Clade: | Terrabacteria |
| Phylum: | Abditibacteriota Tahon, 2018 |
Abditibacteriota is a bacterial phylum[1] previously known as FBP candidatus, which is widespread in extreme environments on Earth, from polar and desert ecosystems to wastewater and contaminated mining sites. The first cultured representative came from Utsteinen in the Sør Rondane Mountains (East Antarctica) and is a chemoheterotrophic, gram-negative, aerobic and oligotrophic bacterium. It has a limited number of carbon sources, optimized metabolism for survival in low nutrient habitats. Extreme resistance against antibiotics and toxic compounds was identified. Phylogenetically, it would be related to the phylum Armatimonadota according to molecular analysis.[2]
References
- ↑ Abditibacteriota NCBI Taxonomy Browser.
- ↑ Tahon, Guillaume; Tytgat, Bjorn; Lebbe, Liesbeth; Carlier, Aurélien; Willems, Anne (2018). "Abditibacterium utsteinense sp. nov., the first cultivated member of candidate phylum FBP, isolated from ice-free Antarctic soil samples". Systematic and Applied Microbiology. 41 (4): 279–290. doi:10.1016/j.syapm.2018.01.009. PMID 29475572. S2CID 3515091.
This article is issued from Wmcloud. The text is licensed under Creative Commons - Attribution - Sharealike. Additional terms may apply for the media files.